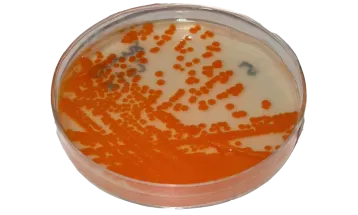
Bactéria comum em gestantes está circulando mais e com maior resistência aos antibióticos

Últimas Notícias

Lula receberá princesa imperial do Japão
Kako de Akishino está em visita a várias cidades brasileiras

STJ mantém condenação de Nikolas por transfobia contra Duda Salabert
Justiça definiu indenização de R$ 30 mil por agressão em 2020

Câmara aprova urgência para criar 49 cargos comissionados em Curitiba
Custo passa de R$ 20 milhões até 2027. Proposta deve ser votada nos próximos dias

Segundo Motta, Congresso não vai aceitar aumento de impostos
Presidente da Câmara cobra que governo pare de focar só em impostos e entre no debate sobre corte de despesas públicas

Saudade não tem idade: Palácio Belvedere em Curitiba – 1941
Palácio Belvedere foi construído entre os anos de 1912 e 1915 por Cândido de Abreu, engenheiro e prefeito de Curitiba

CPI do Professor Monstro deve ser protocolada nesta quinta (12)
Servidor condenado seguiu em atividade por anos; CPI vai apurar omissões da Prefeitura no caso do “Professor Monstro”.
Bactéria comum em gestantes está circulando mais e com maior resistência aos antibióticos
Estudo com o estreptococo do grupo B (GBS) revela grande variabilidade genética entre bactérias, o que pode aumentar o risco de infecções

Sem acordo, CCJ adia votação do novo Código Eleitoral para 9 de julho
Mais 100 emendas foram apresentadas ao projeto, somando um total de 349 Fonte: Agência Senado

Rodovias do Paraná têm tráfego nesta quarta (11)
As autoridades reforçam: o trânsito seguro é construído com atitudes conscientes.

TCE-PR recomenda melhorias na gestão da frota da Polícia Penal
Auditoria realizada pelo Tribunal de Contas identificou diversas falhas estruturais e operações que impactam diretamente a efetividade da política de segurança pública no Paraná

Toledo enfrenta alta de casos respiratórios e adota medidas emergenciais na rede de saúde
A unidade de saúde da Vila Paulista foi a escolhida para centralizar os atendimentos de casos respiratórios

Vereadores cobram prioridade para obras do pedágio no perímetro urbano de Cascavel
Intervenções como viadutos, passarelas e dispositivos de acesso e retorno são demandas antigas, mas que frequentemente acabaram postergadas ou não realizadas na concessão anterior

Paraná registra 87 casos de feminicídio nos primeiros três meses de 2024, aponta estudo
Dados do Lesfem mostram que maioria das vítimas foi agredida por parceiros ou ex-companheiros; especialista destaca importância do combate à violência doméstica

Dino vota a favor da responsabilização de redes por conteúdos ilegais
Até o momento, placar do julgamento está favorável responsabilização

De onde saí tanto dinheiro? Itaipu vai custear quase R$ 900 milhões para concluir obra parada e adquirir novo jardim Universitário da Unila
E não é só, a Itaipu também vai desembolsar R$100 milhões com placas fotovoltaicas para universidades. Além de R$ 19,8 milhões para implantação do novo Campus da IFPR em Maringá